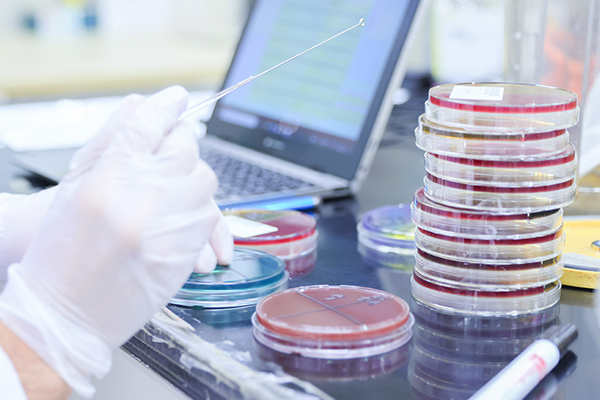
微生物学的検査

臨床検査事業では、病院などの医療機関から届いた検体や、健康診断で採取された血液などを検査し、地域の皆さまの健康をサポートしています。

腸内細菌検査(検便)お申し込みをオンラインで簡単に
食品取扱事業者様や自治体の皆様が、腸内細菌検査(検便)のご依頼をスムーズに行えるようオンラインフォームをご用意しました。
必要事項をご入力いただくだけで、迅速かつ確実に検査準備を進められます。
検査の種類
各検査分野に応じて、必要な機器や装置を使用し、丁寧に検査を行います。検査の内容に合わせて適切な環境を整え、正確な測定・記録に努めています。
血液学的検査

血液を用いて赤血球数や白血球数、ヘモグロビン濃度などを調べ、貧血や炎症の有無を知ることができます。また、顕微鏡を用いて赤血球や白血球などに形態異常がないかなどの検査もします。
免疫学的検査

抗原抗体反応とよばれる免疫反応を応用して、肝炎ウイルス等の感染症検査やインスリン等の内分泌検査、各種腫瘍マーカーの測定をしています。
病理学的検査

手術などで採取された組織から標本を作製し、顕微鏡観察を行うことで病変の診断や腫瘍の有無を判定します。また、尿や喀痰から標本を作製し、悪性細胞の有無などを判定します。
生化学的検査

蛋白や脂質・酵素などの血液や尿などに含まれる成分を化学反応させて、濃度を測定します。 これにより全身状態や各種臓器の異常を調べることができます。
尿・糞便等一般検査

尿を用いて、尿中成分の測定や赤血球や白血球などの有形成分を観察することで腎臓や膀胱などの腎・尿路系の病態把握が出来ます。
また、糞便を用いた大腸がんのスクリーニング検査や、寄生虫検査をしています。 その他関節液や髄液を用いた検査も実施しています。
微生物学的検査
尿や便、喀痰などを用いて、感染の原因となる細菌の種類を調べる検査を行っています。どの菌が関与しているかを明らかにすることで、適切な治療につなげることができます。
遺伝子関連・染色体検査
特定のDNAを抽出・増幅させ分析します。分析した結果は感染症の診断に利用されています。
精度管理
外部精度管理調査への参加について
検査結果が、どの施設で測定しても同じように信頼できるものであることはとても大切です。当センターでは、検査の精度やデータの一貫性を保つため、各種団体の「精度管理調査」に参加し、全国の医療機関とのばらつきを少なくするよう努めています。
- 岐阜県医師会:岐阜県医師会臨床検査精度管理調査
- 日本臨床衛生検査技師会:日臨技臨床検査精度管理調査
- 岐阜県臨床検査技師会:岐臨技臨床検査精度管理調査
- 日本衛生検査所協会:日衛協臨床検査精度管理調査
- 全国労働衛生団体連合会:全衛連臨床検査精度管理調査
岐阜県や医療関連サービス振興会の立入検査を受けています
安心して検査をご利用いただけるよう、当センターでは行政や第三者機関による定期的なチェックを受けています。
施設の設備や検査体制がきちんと整っているか、安全性や品質の面から厳しく確認されています。
医療関連サービスマークを取得
当センターでは、厚生労働省の外郭団体である「財団法人 医療関連サービス振興会」より、検体検査業務に関して「医療関連サービスマーク」の認定を受けています。
このマークは、質の高いサービスを提供するために定められた基準を満たしていることを示すもので、安心してご利用いただける目安のひとつとなっています。
ISO15189を取得
ISO15189:2022認定 RML03400
ISO15189:2022は、臨床検査室の品質(生活の質、医療の質、検査の質)と能力に関する国際標準マネジメントシステム規格です。
この認証を受けたことは検体をお預かりするところから、検査が正しく行われ、報告書をお届けするための仕組み(マネジメントシステム要求事項)と、正しい検査結果を出す技術・能力(技術的要求事項)が国際的な基準を満たしていることを意味します。 当センターは、関わるすべての人にゆるぎない安心を提供するため信頼できる検査データの提供を目指し今後とも努力いたします。